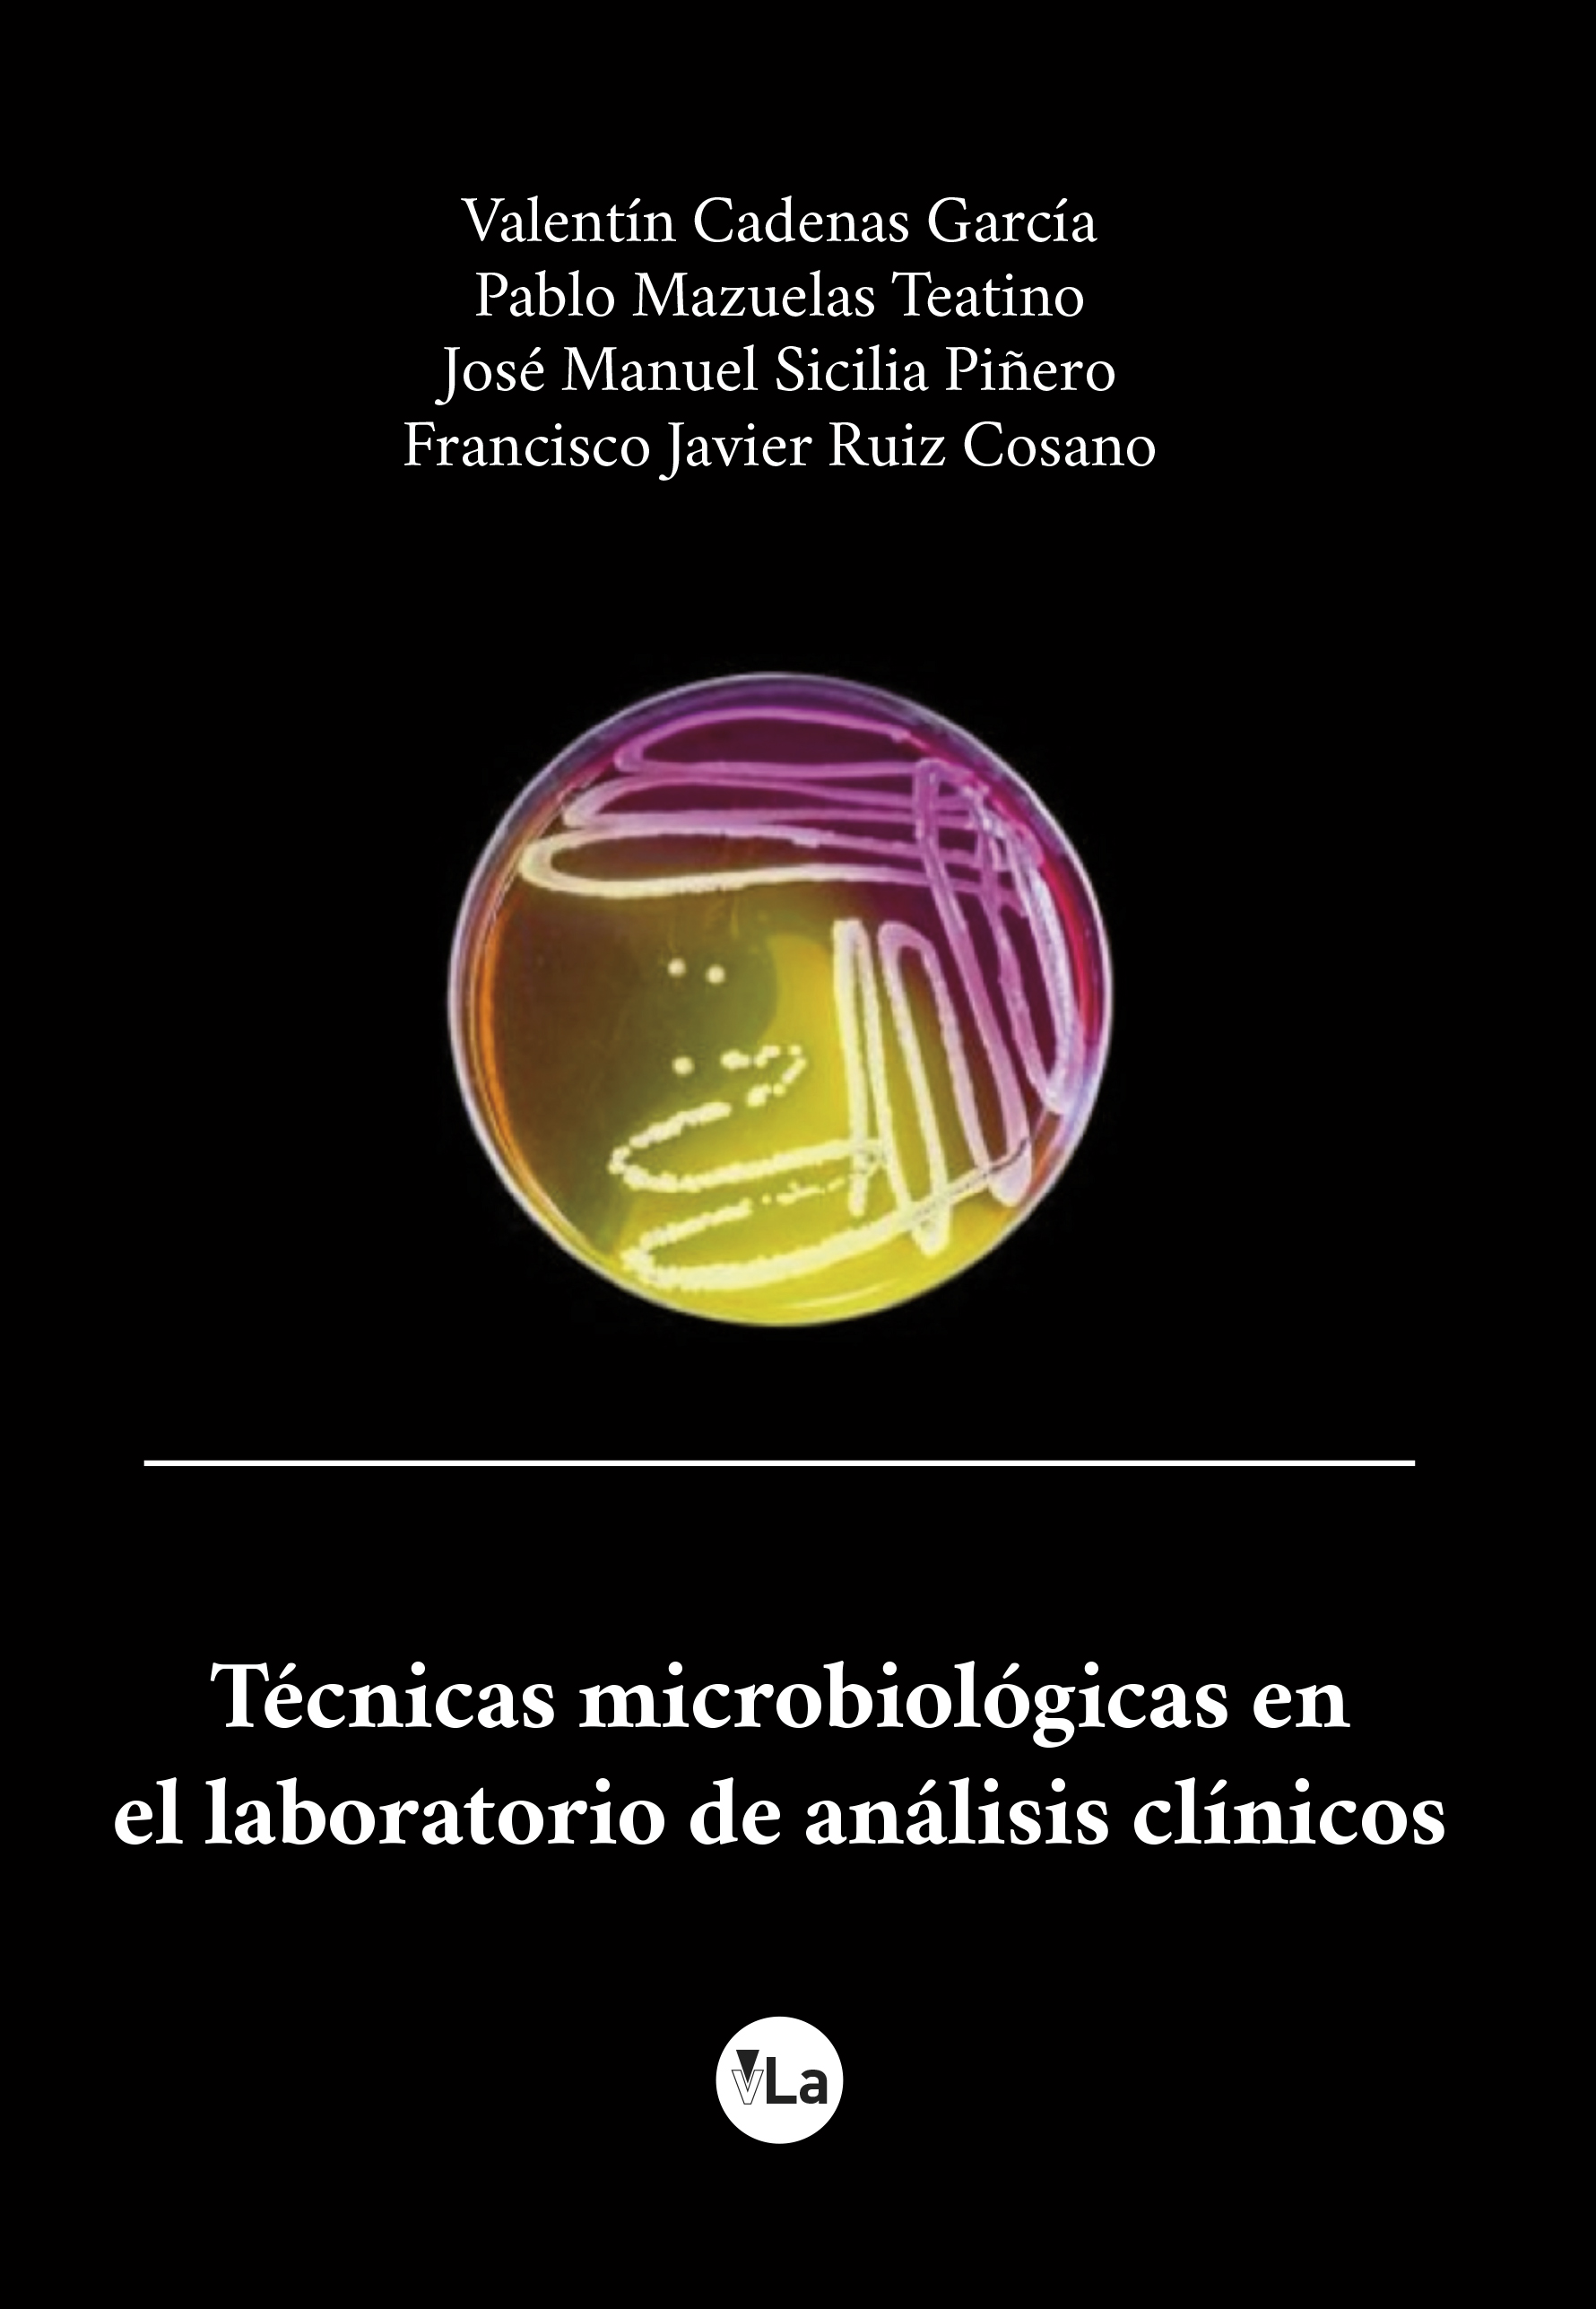
Técnicas microbiológicas en el laboratorio de análisis clínicos

Manejo de la diarrea asociada al Clostridium difficile en el laboratorio clínico
Francisco Javier Ruiz Cosano y Silvia Vega CastañoEditorial: vLaISBN: 9788417286149

Sinopsis
Este manual se presenta como una revisión de la situación actual de la diarrea asociada al Clostridium difficile. Se abordarán temas tan importantes como los cambios de la epidemiología de este mucrorganismo con la diseminación de las cepas hipervirulentas 027 o 078, así como las nuevas técnicas y algoritmos doagnósticos recomendados por distintas sociedades científicas. Se estudiarán además todos los tratamientos disponibles tanto tradicionales como novedosos incluidos en el arsenal terapeutico para el manejo y control de esta infección.
Otros libros de Francisco Javier Ruiz Cosano
-

El laboratorio en el centro de transfusión
Francisco Javier Ruiz Cosanovivelibro lanzamiento -

Insuficiencia suprarrenal y laboratorio clínico
Francisco Javier Ruiz Cosanovivelibro lanzamiento -

Evaluación de la fase preanalítica del laboratorio clínico
Francisco Javier Ruiz Cosanovivelibro lanzamiento -

-
Técnicas microbiológicas en el laboratorio de análisis clínicos
Francisco Javier Ruiz CosanoVivelibro

